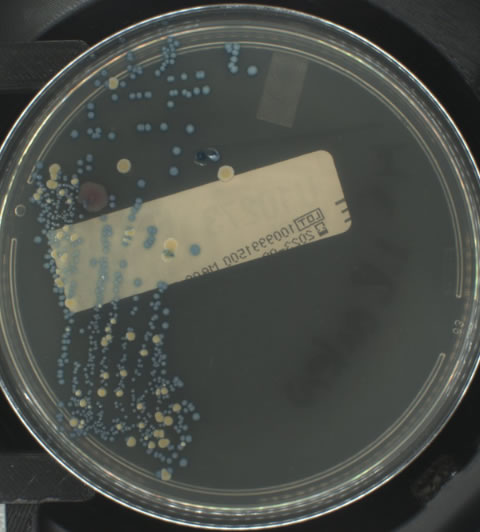

The Ai5 Lab system is a compact, modular, and innovative solution designed to streak, incubate, digitalize, and sort microbiological samples while integrating AI algorithms for growth detection, sample segregation, and real-time alerts.

Microbiology as it happens
Discovering Ai5 lab components

Increase your laboratory’s productivity by automating sample streaking and inoculation processes with the AUTOPLAK automatic streaking and inoculation system. Enhance the system further with our optional subsystems for bi-plate streaking and Gram preparation.

The intelligent incubator AIPLAK digitalises all sample images for efficient interpretation by the laboratory technician. The compact and modular concept, featuring independent cameras and a dual system of image capture and continuous growth monitoring, introduces new and effective tools for workflow management based on the criticality of samples.

The AI Modules platform provides artificial intelligence algorithms that complement the bacteriological digitalisation offered by AIPLAK. From algorithms for continuous monitoring application to those for intelligent interpretation of samples using validated algorithms, it encompasses growth detection, contamination detection, microorganism identification, colony counting, and more.


Advance the efficiency of your laboratory by automating inoculation and plate streaking. Inoculate and streak automatically using AUTOPLAK system. Isolate colonies via different protocols. Standardise streaking methods through the AUTOPLAK automation system.

The intelligent incubation system seamlessly integrates a purpose-built desktop application, ensuring efficient data incorporation, error reduction, and complete digitalisation of the laboratory workflow. Tailored to meet diverse laboratory requirements, this application, when coupled with advanced artificial intelligence algorithms (Ai5 Lab Modules), not only manages and identifies each sample digitally but also enhances overall operational efficiency by eliminating the need for physical contact with individual samples, thus optimising laboratory processes for greater precision and productivity.

Engineered with versatility in mind, the Ai5 Lab system is meticulously crafted to seamlessly accommodate the requirements of diverse laboratories, varying sample volumes, and a multitude of protocols. Its compact design and modular approach not only ensure optimal utilization of laboratory space but also facilitate a swift and effortless installation process, contributing to an overall streamlined and efficient workflow in the laboratory environment.
The intelligent incubation system is the only system on the market equipped with 2 complementary imaging systems. A first continuous monitoring system that allows uninterrupted monitoring of sample growth, being capable of generating alarms as soon as growth is detected in the sample. The second system captures the overhead image, digitalising the sample and executing artificial intelligence algorithms to determine the characteristics of that growth. This advanced platform that combines time-based and growth-based management protocols, provides the laboratory with a unique tool to address emergency situations, to efficiently optimise workflow processes thus contributing to a more effective operation and accelerated results in the laboratory.

The external imaging system integrated into the incubator not only facilitates early detection of sample growth but also incorporates a cutting-edge feature— the generation and transmission of timely alarms to the laboratory technician. This pioneering tool, standing out as a unique offering in the market, seamlessly combines a revolutionary hardware concept with an advanced algorithm for continuous monitoring of sample development. By seamlessly integrating these elements, it not only ensures early warning capabilities but also signifies a significant leap forward in enhancing the overall efficiency and responsiveness of laboratory operations.

Incorporate various artificial intelligence modules into your laboratory operations and optimize the utilization of your laboratory technicians for higher-value tasks. Sener provides the Ai5 Lab Modules platform, offering algorithms tailored to match your consumables and workflow seamlessly. Some of these modules include continuous monitoring systems, growth/no-growth detection, colony counting, microorganism detection, morphology analysis, contamination identification, and more.
It’s not about automation,
it is about adding value through automation
Contact us
Experience the future of clinical microbiology with Sener’s Ai5 Lab System: The Ultimate in Compact, Modular, and Innovative Automation. Accelerate Detection with Continuous Reading Excellence!